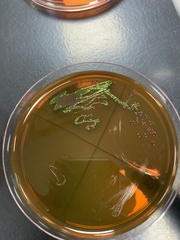
Escherichia coli
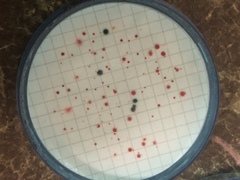
Escherichia coli
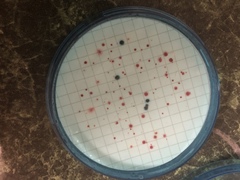
Escherichia coli
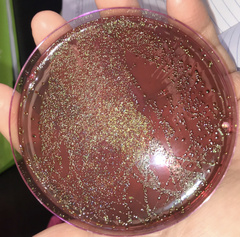
Escherichia coli
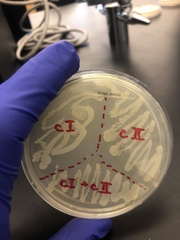
Escherichia coli
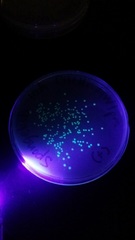
Escherichia coli
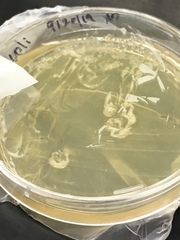
Escherichia coli
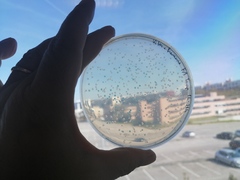
Escherichia coli
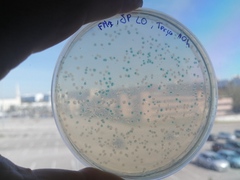
Escherichia coli
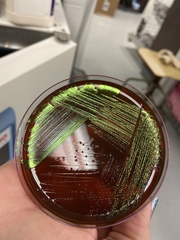
Escherichia coli
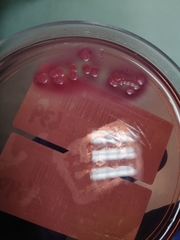
Escherichia coli
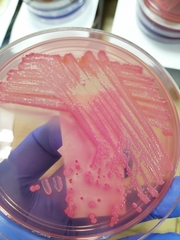
Escherichia coli
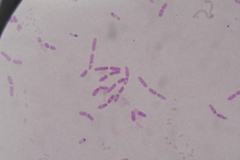
Escherichia coli
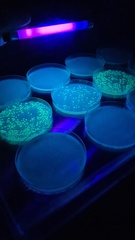
Escherichia coli
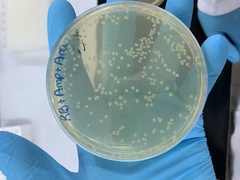
Escherichia coli
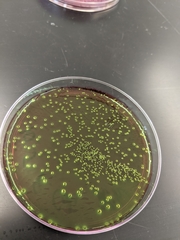
Escherichia coli

©herexton, some rights reserved (CC-BY-NC)
©bmaher222, some rights reserved (CC-BY-NC)
©jzlloyd, some rights reserved (CC-BY-NC)
©Alyssa Irvin, some rights reserved (CC-BY-NC)
©Sabarni Sarker, some rights reserved (CC-BY-NC-ND)
©Pedro Ramalho, some rights reserved (CC-BY-NC)
©Howard Horne, some rights reserved (CC-BY-NC)
©Howard Horne, some rights reserved (CC-BY-NC)
©Andrés Ramírez-Barrera, some rights reserved (CC-BY)
©Ramóna Molnár, some rights reserved (CC-BY-NC)
©Ramóna Molnár, some rights reserved (CC-BY-NC)
©Ramóna Molnár, some rights reserved (CC-BY-NC)
©Ramóna Molnár, some rights reserved (CC-BY-NC)
©Bonnie Semmling, some rights reserved (CC-BY)
©Karl Feng, some rights reserved (CC-BY-NC)
©jsikkema631, some rights reserved (CC-BY-NC)
©Justin Paulin, some rights reserved (CC-BY)
©Steven Kurniawidjaja, some rights reserved (CC-BY-NC)
©Elisha Barkanov, some rights reserved (CC-BY-NC)
©Sequoia Janirella Wrens, some rights reserved (CC-BY-NC)
©Bobby McCabe, some rights reserved (CC-BY)
©Daniel Raposo, some rights reserved (CC-BY-NC)
©Daniel Raposo, some rights reserved (CC-BY-NC)
©rbrewer, some rights reserved (CC-BY-NC)
©meganton, some rights reserved (CC-BY-NC)
©aizuddinzailani, some rights reserved (CC-BY-NC)
©aizuddinzailani, some rights reserved (CC-BY-NC)
©Sam Hartzler, some rights reserved (CC-BY-NC)
©Karl Feng, some rights reserved (CC-BY-NC)
©alejandromg, some rights reserved (CC-BY-NC)
©alejandromg, some rights reserved (CC-BY-NC)
©alejandromg, some rights reserved (CC-BY-NC)
©citywildlifewarriortulsaok, some rights reserved (CC-BY-NC)
©microbialsoup, some rights reserved (CC-BY-NC)
©Karl Feng, some rights reserved (CC-BY-NC)
©Ansel Oommen, some rights reserved (CC-BY-NC)